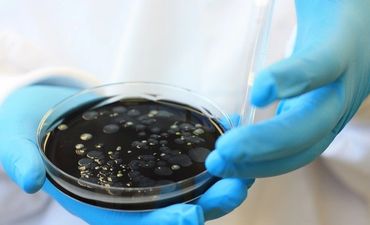

We are here to give you piece of mind and take responsibility for all of your water hygiene needs - click below.

We can assess your site and evaluate your requirements to be compliant with the latest HSE guidelines - click below.

We have the expertise to carry out all necessary works in house we do not use sub contractors and all our services are listed on our page - click below.
We are Pure Clear Water. We are always here for our customers, so feel free to book a free consultation visit, call during normal business hours or email anytime to book and for free advise. Our email is admin@pureclearwater.co.uk
Open today | 08:00 – 17:00 |